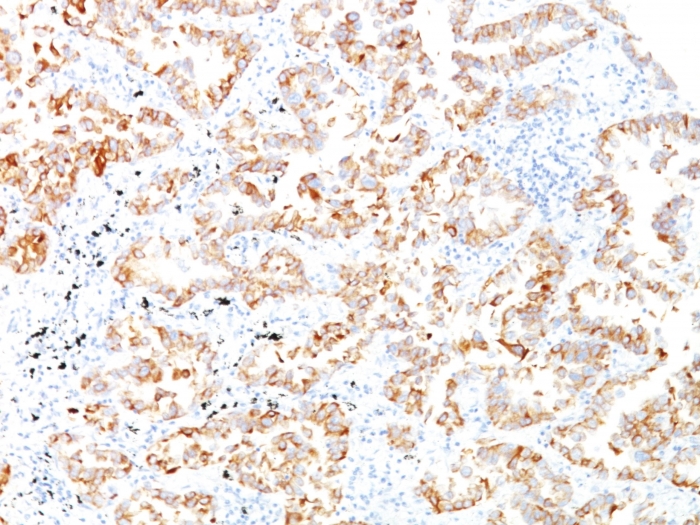

Formalin-fixed, paraffin-embedded human Lung SCC stained with Cytokeratin 7 Monoclonal Antibody (SPM270).

Immunofluorescence Analysis of HeLa cells labeling Cytokeratin 7 with KRT7 Mouse Monoclonal Antibody (SPM270) followed by Goat anti-Mouse IgG-CF488 (Green). The nuclear counterstain is Reddot (Red).
It recognizes an intermediate filament protein (IFP) of 55kDa, which is identified as cytokeratin 7. This MAb is highly specific to cytokeratin 7 and shows no cross-reaction with other IFPs. Cytokeratin 7 is a basic cytokeratin, which is found in most glandular and transitional epithelia but not in the stratified squamous epithelia. Keratin 7 is expressed in the epithelial cells of ovary, lung, and breast but not of colon, prostate, or gastrointestinal tract. This MAb is highly useful in distinguishing ovarian carcinomas (keratin 7+) from colon carcinomas (keratin 7-).
There are no reviews yet.